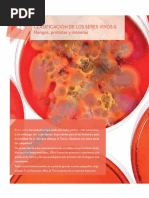

0% encontró este documento útil (0 votos)
58 vistas3 páginasFrida Kahlo: Autorretrato y Significado
Este autorretrato de Frida Kahlo muestra los símbolos del dolor de su divorcio reciente de Diego Rivera, incluyendo una corona de espinas y animales como un mono y un gato negro.
Cargado por
Canela BravoDerechos de autor
© © All Rights Reserved
Nos tomamos en serio los derechos de los contenidos. Si sospechas que se trata de tu contenido, reclámalo aquí.
Formatos disponibles
Descarga como DOCX, PDF, TXT o lee en línea desde Scribd
0% encontró este documento útil (0 votos)
58 vistas3 páginasFrida Kahlo: Autorretrato y Significado
Este autorretrato de Frida Kahlo muestra los símbolos del dolor de su divorcio reciente de Diego Rivera, incluyendo una corona de espinas y animales como un mono y un gato negro.
Cargado por
Canela BravoDerechos de autor
© © All Rights Reserved
Nos tomamos en serio los derechos de los contenidos. Si sospechas que se trata de tu contenido, reclámalo aquí.
Formatos disponibles
Descarga como DOCX, PDF, TXT o lee en línea desde Scribd